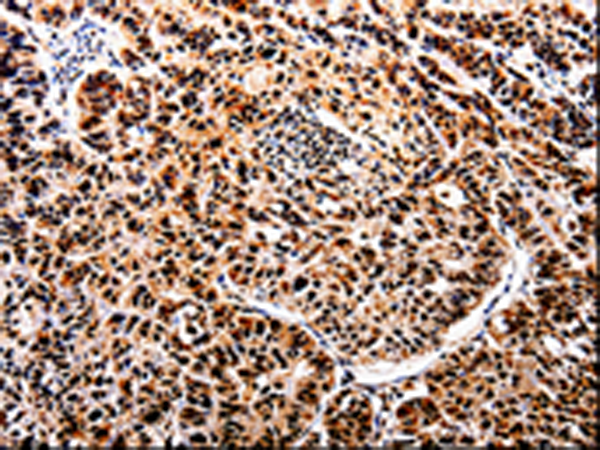

中文名稱:兔抗APIP多克隆抗體
|
Background: |
APIP is an APAF1 (MIM 602233)-interacting protein that acts as a negative regulator of ischemic/hypoxic injury.The protein highly expressed in skeletal muscle and heart and binds to the CARD of Apaf-1 in competition with caspase-9. Exogenous APIP inhibits cytochrome c-induced activation of caspase-3 and caspase-9, and suppresses cell death triggered by mitochondrial apoptotic stimuli through inhibiting the downstream activity of cytochrome c released from mitochondria. |
|
Applications: |
ELISA, WB, IHC |
|
Name of antibody: |
APIP |
|
Immunogen: |
Fusion protein of human APIP |
|
Full name: |
Probable methylthioribulose-1-phosphate dehydratase |
|
Synonyms: |
APIP2, CGI29, CGI-29, MMRP19, dJ179L10.2 |
|
SwissProt: |
Q96GX9 |
|
ELISA Recommended dilution: |
500-5000 |
|
IHC positive control: |
Human lung cancer |
|
IHC Recommend dilution: |
25-100 |
|
WB Predicted band size: |
27 kDa |
|
WB Positive control: |
Mouse heart tissue |
|
WB Recommended dilution: |
200-1000 |

購物車
購物車 幫助
幫助
 021-54845833/15800441009
021-54845833/15800441009
